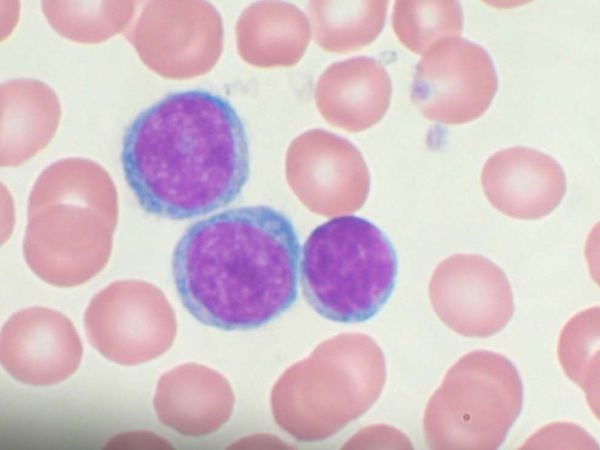
Ensayo clínico en Reino Unido marca hito en tratamiento sin quimioterapia para la leucemia linfocítica crónica.

¿Puede el cerebro ser el gran director de orquesta del envejecimiento? Nuevas investigaciones sugieren que sí. Y hay un actor inesperado en esta historia: las células zombis. Estas células, llamadas senescentes, ya no se dividen ni cumplen su función, pero consumen el doble de energía que las células jóvenes. Lejos de estar inactivas, parecen activar señales inflamatorias que afectan a todo el cuerpo, lo que podría explicar por qué el envejecimiento acelera mientras el metabolismo disminuye.
LEE TAMBIÉN EN CONCIENCIA 24.7:
- Revolución médica: nueva terapia sin quimio mejora tratamiento de leucemia en adultos
- ESA logra el primer eclipse solar artificial y muestra imágenes inéditas de la corona del Sol
- ¿Por qué está aumentando el cáncer de apéndice en jóvenes?
Este descubrimiento llevó a los investigadores Martin Picard y Gabriel Sturm, de la Universidad de Columbia, a proponer el modelo de conservación de energía cerebro-cuerpo, una teoría que plantea que, a medida que algunas células requieren más energía, el cerebro redistribuye recursos a costa de otras funciones, provocando signos de envejecimiento como canas o pérdida muscular.
El estrés, un acelerador biológico
El cerebro no solo responde al envejecimiento interno, también reacciona al entorno. Estudios liderados por Elissa Epel y otros científicos revelaron que el estrés crónico acorta los telómeros, las estructuras que protegen el ADN, y acelera procesos relacionados con la edad como la inflamación o la senescencia celular.

Incluso situaciones como el estrés laboral o el cuidado prolongado de personas enfermas han demostrado tener impactos medibles a nivel celular. Otros estudios en animales refuerzan la idea: ratones y monos sometidos a estrés social desarrollan más signos de envejecimiento y activan genes vinculados a la inflamación.
GDF15: ¿el mensajero entre células y cerebro?
Una molécula clave en este proceso podría ser la GDF15, una citoquina relacionada con enfermedades y condiciones como el cáncer, el Alzheimer y la pérdida de apetito. Lo interesante es que su receptor está solo en el cerebro, lo que sugiere que es una especie de “aviso celular” que informa al cerebro sobre el estrés interno.
El equipo de Picard encontró que los niveles de GDF15 aumentan en la sangre y la saliva tras episodios de estrés psicológico, lo que apoya la hipótesis de que el estrés es un proceso costoso en términos energéticos y envejece al cuerpo desde dentro.
¿Qué se puede hacer?
Aún no hay soluciones mágicas, pero sí pistas. El ejercicio físico, por ejemplo, ha mostrado efectos positivos en la longitud de los telómeros y en la resiliencia frente al estrés. Además, se está considerando seriamente incorporar el estrés como variable en ensayos clínicos de fármacos anti-edad.

Como dice la investigadora Epel:
“Siempre buscamos una única medida del envejecimiento, como los telómeros o el reloj epigenético. Pero la biología no es tan simple”.